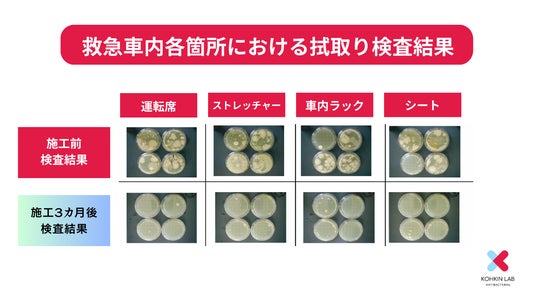

突然の災害時にも対応可能な新プランが好評【医療施設向け感染症対策】/2024年4月28日より本格スタート

救急車内の感染症対策
株式会社HONU(東京都港区,代表:内田賢一)は、全国の消防署を対象に救急車内での感染リスクを低減させるため『救急車向け接触感染対策』を提案いたします。
この対策では、現状のリスクと対策後のリスク減を視覚化することで、明確な汚染ポイントが確認可能です。
感染防止対策マニュアルの改訂
(救急隊員個人の感染リスク)
救急隊員の感染リスクを最小限に抑えるために、適切な感染対策の装備(感染防止衣)と訓練が充実
(救急車輛内の感染リスク)
車両及び資器材に関しては汚染が多岐にわたり、汚染を把握することは難しく防ぐことも困難な状況は変わらない。
インバウンド増加による新興感染症の増加を見据えた対策

訪日外客推移
KOHKIN LABオリジナル 『救急車内の衛生環境の可視化』
- 培養試験:車内の拭き取り試験実施 (第三者機関による培養試験)
- KOHKIN LABによる半年毎施工
- 緊急時や被災時対応できるように機材と溶剤の常設
救急車内における拭き取り検査結果
専門機関によって示された高い抗菌力
今回の感染症対策では、医療現場での感染予防のために開発された3種の触媒反応を利用した抗菌製品を使用しています。その有効性と安全性から、救急車両をはじめとする警察・消防などの災害救助の現場において、効果の高い感染症対策として全国で導入されています。

KOHKIN LAB導入事例
KOHKIN LABへのお問合せ方法
ご相談のながれ(まずは電話かメールにてご相談ください)
- 対応エリア・日本全国の消防署および医療施設など
- 問い合わせ先・mail : info@kohkinlab.jp・電話番号:03-6885-5737・問合せフォーム:https://form.run/@honucare-1670988198
【会社概要】
商号 :株式会社HONU
代表者 : 代表取締役 内田 賢一
所在地 : 〒107-0052 東京都港区⾚坂9-1-7
設立 : 2008年3月
事業内容: 医療施設向け院内感染対策及び防災ECサイト運営
資本金 : 1000万円
URL : https://honucare.co.jp/
【KOHKIN LABについて】
災害救助や医療現場などで働く人々を、感染症リスクから防御するために開発されたサービスを提供。 「感染ゼロを目指して」をコンセプトに、法医学の現場で生まれた抗菌製品「デルフィーノ」のほか、空気感染対策製品を取り扱う。 施工実績は、医療施設中心に院内感染対策を行い、宿泊施設、学校、保育園、プロスポーツ施設など多数。また消臭についても多くの実績を保有し、2023年8月ホテル向け消臭サービス『触媒のチカラ』をローンチしています。